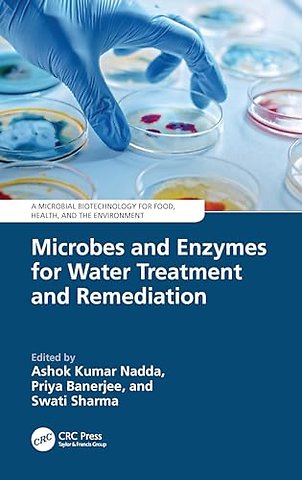

Microbes and Enzymes for Water Treatment and Remediation
Samenvatting
The book provides up-to-date insights into the potential of microbial and enzyme-based processes for wastewater treatment, addressing challenges and limitations while offering alternative methods for effluent treatment and water reclamation.